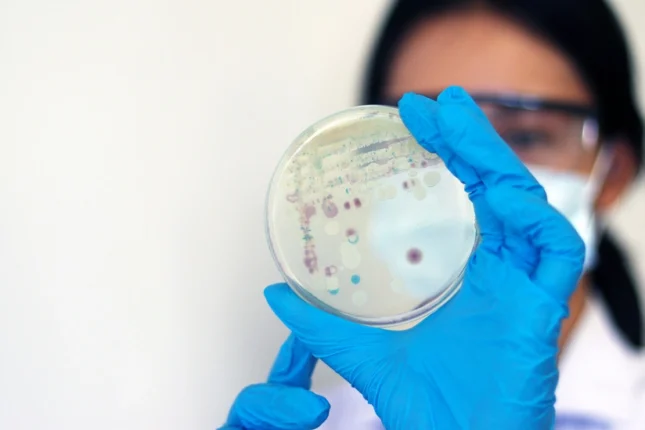

Предсказания Нострадамуса и Ванги: «Будет ли Третья мировая война?»
Пророчества знаменитых предсказателей.

В мире происходит всё больше ужасных событий и каждый из нас хоть раз задумывался: «Будет ли Третья мировая война?» Вот, что на этот счёт говорили самые знаменитые пророки…
Мишель Нострадамус

«Кровь, человеческие тела, покрасневшая вода, на землю падает град… Я чувствую приближение большого голода, он будет часто отходить, но потом станет всемирным».
Самый знаменитый пророк предсказал, что война придёт с территории современного Ирака и продлится 27 лет.
Серафим Вырицкий

Очевидцы рассказывали, что старец, предсказавший в 1927 году Вторую мировую, после её окончания сказал, что на этом конфликты на Земле не закончатся.
«Нет, это еще не все. Еще будет страху больше, чем было. Вы еще встретите ее…»
Ванга

«Человечеству уготовано ещё много катаклизмов и бурных событий… Грядут тяжкие времена, людей будет разделять их вера… Древнейшее учение придёт в мир… Меня спрашивают, когда это случится, скоро ли? Нет, не скоро. Ещё Сирия не пала…»
Это предсказание было сделано Вангой в 1978 году, когда никто ещё не знал, какие ужасы уготованы этой арабской стране. Толкователи считают, что в этом пророчестве идёт речь о войне Запада и Востока, которая начнется на религиозной почве на территории Сирии.
~~~@@*@@~~~
Не менее ужасными вам покажутся пророчества Ионы Одесского и Григория Распутина…
Иона Одесский

«Будет. Через год после моей смерти все и начнется. В одной стране, меньшей, чем Россия, возникнут очень серьезные настроения. Продлится это два года и закончится большой войной. А потом будет русский царь»
Так Иона Одесский ответил на вопрос о том, будет ли Третья мировая война. Старец умер в 2012 году.
Григорий Распутин

«По дорогам Европы поползут три голодных змеи, оставляя за собой пепел и дым, у них один дом – и это меч, и у них один закон – насилие, но, протащив человечество через пыль и кровь, они сами погибнут от меча же»
Толкователи считают, что речь здесь идёт о Третьей мировой войне.
~~~@@*@@~~~
Вот, что о перспективе начала Третьей мировой войны заявила Сара Хоффман, предсказавшая Америке теракт 11 сентября 2001 года…
Сара Хоффман

«Я видела российские войска, которые вторглись в Соединенные Штаты Америки. Я видела их… главным образом на Восточном побережье… Я также видела, что китайские войска вторглись на Западное побережье… Это была ядерная война. Я знала, что это происходит во всем мире. Я не видела большую часть этой войны, но она была не очень продолжительной…»
По словам Хоффман, Россия и Китай, вероятно, проиграют в этой войне.